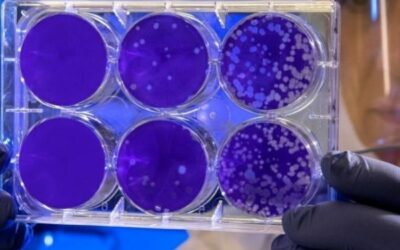
العلم وراء الأكسجين المضغوط وتجديد الخلايا

المدونة
طرق علاج بقع الشمس والوقاية منها
البقع الداكنة بعد الشمس: طرق العلاج والوقاية البقع الداكنة بعد الشمس تعد من أكثر مشكلات التى تواجه البشرة وتعد تحدى للتخلص منها خاصة في فصل الصيف...
تجارب حقيقية للنساء في التجميل المهبلي
تجارب حقيقية في التجميل المهبلي: ماذا تقول النساء أصبح التجميل المهبلي إجراء تجميلي متبع لمعظم النساء للحفاظ على أنوثة وجمال دائم، وسوف نتعرف في...
االأكسجين المضغوط ثورة جمالية للبشرة والشعر
فوائد الأكسجين المضغوط للبشرة والشعر ثورة في العناية الجمالية دائماً ما نبحث عن أفضل الحلول التجميلية للبشرة والشعر دون اللجوء إلى الجراحة مع أقل...
العلم وراء الأكسجين المضغوط وتجديد الخلايا
الأكسجين المضغوط والتجديد الخلوي: العلم وراء الشفاء السريع الأكسجين المضغوط والتجديد الخلوي في الجسم أثبت أنه من أكثر العلاجات التكميلية غير...
كل ما يهمك معرفته عن فايروس الورم الحليمي
كل ما يخص الورم الحليمي ولقاحه دليلك الشامل من الخبراء الورم الحليمي يصيب الإنسان نتيجة العدوى بفيروس يسمى HPV human papillomavirus وهو فيروس له...
أهمية التطعيمات قبل الحج
أهمية التطعيمات قبل الحج مع اقتراب موسم الحج وتوافد الحجاج من مختلف البلاد حول العالم لأداء المناسك تزداد فرص العدوى وخاصة والأوبئة المستوطنة في...